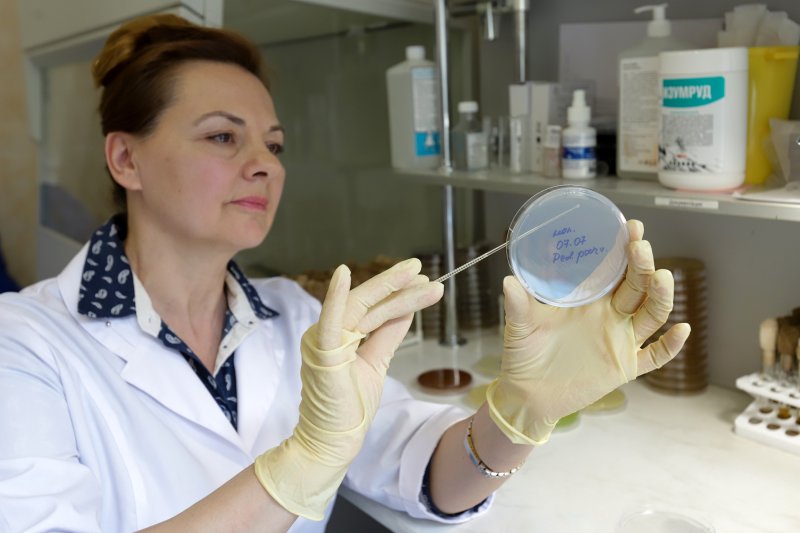

На ферме Валаамского монастыря выпустили опытную партию необычного йогурта — на закваске с использованием штамма лактобактерий «образца 1940 года». Штамм получен из молока в бутылке, пролежавшей более 80 лет на дне Ладоги, на борту затонувшего судна «Walamon luostari» («Валаамский монастырь»).
Подарок от дайверов
Хорошо укупоренные бутылки с молоком нашли и подняли дайверы клуба «Диво» из Орла в Большой Никоновской бухте Валаама.
Две бутылки подарили журналисту «РГ». Одна пошла на изготовление йогурта. Вторая — на сугубо научные цели. В частности, выяснилось, что обнаруженные бактерии можно использовать в качестве натурального биоконсерванта и что их было бы полезно добавлять в схему лечения дойных коров от мастита. А еще — они обладают противоопухолевой активностью.
Скажу сразу: йогурт получился отменный (пробовали и работники фермы, и монахи, и лично игумен монастыря епископ Троицкий Панкратий, и пресс-служба обители, и ветеринары). И, конечно, я. Вердикт одинаковый: вкусный, нежный, хорошей густоты. А в петербургский филиал «РГ» еще доставили и опытный образец (пока именно образец) сметаны — тоже с использованием в закваске штамма 1940-го года. Журналисты все съели: отличная сметана.
И важный момент: чтобы пазл этой истории сложился, в ней принимали участие много хороших людей из разных организаций. От монахов до ученых института с мировым именем.
Тайны глубин
Судно «Валаамский монастырь» построено в 1860-х годах на одной из шведских верфей. Первоначально имело другое название. Владельцем корабля стал купец, занимающийся лесозаготовками. В 1931 году он обанкротился и судно выставили на торги. Новым владельцем и стал Валаамский монастырь, который переоборудовал корабль под перевозку паломников.
Перед Зимней войной его забрали для нужд военно-морского флота Финляндии (до 1940 года архипелаг территориально принадлежал этой стране). Зимой 1939-1940 года судно стояло в Большой Никоновской бухте. Одна из бомб советской авиации попала в корму. Еще две упали рядом. Произошел мощный взрыв, на судне начался пожар. И оно затонуло.
Только спустя почти 80 лет, в 2019 году, судно случайно обнаружили дайверы из Орла. С тех пор они каждый год приезжают на Валаам, проводят изыскания. Находки пополняют экспозиции сразу трех музеев — Валаамской обители и двух в Орле — Военно-исторического и дайвинга. Работы ведут в контакте со специалистами Института археологии РАН. В частности, с глубины были подняты: бронзовый крест с мачты, чайник, серебряная ложка, подсвечник, мясорубка.
«Любой найденный предмет на дне, который не имеет истории, на мой взгляд, бездушный предмет. А артефакт с историей — это музейный экспонат. Если, например, якорь, бутылка, даже пуговица и башмак имеют клейма, можно определить производителя, время», — подчеркнул начальник экспедиции Сергей Куликов.
Скисло — и только
В прошлом году я съездила с дайверами на погружение. В тот раз с борта затонувшего судна достали много чего: в том числе противогаз и лыжную палку, принадлежавшие финским военным, обувь, эмалированное ведро, на дне которого стояла печать с гербом Швеции. «Вы нам принесли удачу», радовались дайверы.
Бутылки с молоком ребята из Орла находили и раньше. Попросила поднять их для «РГ». Подняли! Две подарили. Бутылки — оригинальные, с узким горлышком совсем не похожи на советский образец аналогичной тары. Вернувшись на остров, сразу пошла на валаамский свечной мини-завод, где крышки бутылок отец Евтихий залил настоящим воском. Чтобы уж на все 100 процентов при перевозке не проникла современная микрофлора. Перестраховалась.
В самой находке на затонувшем корабле молочных бутылок нет ничего удивительного. Интересно другое: молоко сохранилось во вполне хорошем виде: только лишь скисло и разделилось на фракции. То есть, не зная подробностей, увидев бутылку, можно было сказать, что ей всего-то неделя-две от роду.
И еще важное уточнение: зимой 1940 года монахи были вынуждены покинуть Валаам, уйти вглубь Финляндии, основав там Новый Валаам. С собой они захватили добра по максимуму. И не только церковную утварь, но и коров. Возрождение монастыря на его исконном месте (архипелаг давно стал российским) началось в 1989 году с прибытия на остров первых монахов. Постепенно стали восстанавливать скиты, храмы, ферму. Ныне обитель имеет современную ферму, в которой содержится более 70 коров, а также козы, куры, бараны. А для души — два енота и две альпаки. Есть своя сыроварня, выпускающая йогурт, сметану, творог, разные сорта сыра. Все пришлось создавать заново. Поэтому любая информация о предшествующем хозяйстве является ценной.
Холодильник высшего класса
Итак, одна бутылка была доставлена в НИИ эпидемиологии и микробиологии имени Пастера Роспотребнадзора РФ. Честно говоря, не ожидала, что ученые смогут найти что-то интересное. Почти 80 лет на дне — все микроорганизмы должны были почить в бозе.
Но выяснилось: условия на дне Ладоги оказались отличным консервантом! Прежде всего, достаточно стабильно-низкая, но плюсовая температура весь год (до плюс 6 градусов). Положительными сохраняющими факторами стала темнота, отсутствие воздуха, хорошая жирность продукта. В общем, микроорганизмы не умерли, а впали в анабиоз. И в лабораторных условиях «проснулись».
Исследования проводили с помощью классических бактериологических и молекулярно-генетических методов. Скажу сразу: ничего опасного в молоке не нашли. Зато обнаружили штаммы нескольких видов бактерий. И первую скрипку играет штамм Pediococcus parvulus. Pediococcus — это род грамположительных молочнокислых бактерий из семейства лактобактерий.
«Особенно нас удивила толерантность штаммов к низкой температуре, — рассказала заведующая лабораторией медицинской бактериологии НИИ Пастера Людмила Краева. — Мы их, как положено, сначала пытались размножить при температуре 37 градусов. Нет. Зато они стали прекрасно размножаться при температуре от 10 до 25 градусов. Это следствие нахождения на дне Ладоги в течение более восьми десятилетий. То есть штаммы продемонстрировали удивительную устойчивость и способность выдерживать длительные периоды метаболического покоя (когда все процессы сведены практически к нулю) в условиях экстремального для них стресса».
Бактерии Pediococcus parvulus имеют большое значение в пищевой и биотехнологической промышленности благодаря своей способности вырабатывать молочную кислоту. Поэтому их используют в качестве заквасочных культур для производства ферментированных пищевых продуктов (квашеной капусты, мяса). Молочная кислота и бактериоцины, такие как педиоцин, способствуют укреплению здоровья кишечника. Они усиливают иммунную защиту человека, оказывают противовоспалительное действие. Что касается конкретно валаамского молока — их штаммы подавляют рост патогенных микроорганизмов. Кстати, бактериоцины проявляют и противоопухолевую активность in vitro (то есть в пробирке), нападая на раковые клетки.
«Для нас, как для ученых, представляет интерес эволюция этих бактерий. Хотим сравнить штаммы, которые существовали 80 лет назад, с теми, которые существуют сегодня. Мы уже брали молоко с различных современных ферм — и не нашли их. Пока что «ближайшими родственниками», которых нам удалось обнаружить, оказались штаммы, содержащиеся в закваске для хлеба», — отметил заведующий лабораторией метагеномных исследований Дмитрий Полев.
Ученые планируют сравнить штаммы бактерий, содержащихся в бутылке, поднятой со дна Ладоги, во-первых, с теми, которые присутствуют в молоке валаамской фермы дня сегодняшнего. Во-вторых, если дайверы смогут поднять с затонувшего судна еще бутылки, — то и с бактериями, содержащимися в других бутылках молока. Возможно, нас ждут новые открытия.
Первым стал йогурт
«Ожившие лактобактерии» поставили передо мной новую задачу: нельзя ли, раз они живы-здоровы и активно размножаются, сделать на их основе закваску «образца 1940 года»?
Судьба свела меня с профессором Санкт-Петербургского Государственного университета ветеринарной медицины Еленой Корочкиной, которая в этом году стала лауреатом премии президента России за прорывные исследования в животноводстве. Да, та самая, которой как молодому ученому премию вручал лично президент. И удивился ее рассказу, что в России разводят быков весом в одну тонну.
Во время интервью с Еленой выяснилось: она разрабатывает витаминно-минеральные комплексы для коров, основываясь на индивидуальном подходе к животным. Разработки апробируют и на валаамской ферме. Молодой лауреат заинтересовалась «нашим молоком» и познакомила с индустриальным партнером университета — компанией «Биотроф». Им я и передала вторую бутылку молока.
«Мы успешно работаем с валаамской фермой, — сообщил директор компании, доктор биологических наук Георгий Лаптев. — В том числе и поставляем им силосные закваски. То есть в силос добавляют не какую-то «химию», а молочнокислые бактерии, которые и являются естественным консервантом».
Специалисты выделили из «нашего» молока перечень штаммов различных бактерий. Тоже не нашли ничего опасного. Оценили высокое качество продукта: с хорошей жирностью (около 5 процентов), прекрасно сохранившееся. Стали размножать их. Получилось. Более всего их заинтересовали штаммы Enterocjccusfaecium, которые способны значительно улучшить вкус молочнокислой продукции. Совместно с руководством валаамской фермы было принято решение: первым продуктом станет йогурт (йогурт уже давно выпускается на ферме и было интересно сравнить его с йогуртом, история которого восходит к 1940 году).
Закваска была готова, и в качестве эксперимента на ней в Петербурге стали делать йогурт (молоко закупали у разных фермеров, чтобы разработать оптимальный вариант составляющих закваски). Как пояснили разработчики, брали молоко, вводили при определенных условиях вариант закваски и уже через 6-8 часов получали йогурт. Наконец идеальный вариант был найден. И закваска, из которой можно было сделать йогурт на основе размноженных штаммов 1940 года, была отправлена на Валаам со всеми полагающимися документами, подтверждающими ее безопасность.
Дальше начался самый волнительный этап: апробация закваски на валаамской ферме. Точнее — на ее сыроварне.
Густой и нежный
Сыроварня находится в соседнем с коровником помещении. Так что молоко «не залеживается»: с дойки по трубам поступает сразу в чаны сыроварни.
Но сначала заглянем в коровник. Идеально чисто. Коров здесь холят, лелеют, моют. Чтобы животным не было скучно, им включают духовную музыку. Внимательно слушают. Иногда им и на дудочке играют: так что изображенный на этикетке валаамских продуктов монах с дудочкой — не абстрактный образ, а вполне себе конкретный. Игру на дудочке ввел в обиход отец Авраам, ныне работающий на главной усадьбе. Но у него есть преемники.
У каждой коровы — личное меню. Индивидуальность — фактор важный. Если давать те же витаминно-минеральные добавки на стадо в общем — будут съедать вкусняшки только лидеры, остальным может и не достаться. А при индивидуальном подходе просто: вот твой силос, вот твои витаминки. Корова из соседнего стойла твое не съест. В теплое время все — на выпасе, едят сочную траву.
Вот на молоке от этих вполне себе счастливых коров и сделали опытную партию йогурта. Руководитель духовно-просветительского центра «Свет Валаама» отец Марк присутствовал на всех этапах изготовления.
«Очень волновались, — делится впечатлениями отец Марк. — Удивительное чувство: микроорганизмы, столько лет лежавшие на дне Ладоги, и тут — возродились, размножились. Мы словно окунулись в 1940-й. Как проходил процесс закваски? Еще теплое молоко, только что полученное от коров, подогрели, вылили в большую емкость, в которую добавили закваску. Емкость герметично закрыли и поместили в чан с горячей водой, чтобы внутри емкости максимально долго сохранялась высокая температура. Через 8 часов продукт начали пробовать, разлили по чашкам. Дегустаторов оказалось много. Проверку на органолептические показатели новый йогурт прошел на отлично».
Сейчас новый продукт готовят к массовому производству. Есть нюансы: как технические, так и юридические. В каком количестве будут готовить — еще не решено. Как узнаю — расскажу.
Справка «РГ»
На изготовление традиционного валаамского йогурта уходит 100 литров молока в неделю. Пробовавшие и современный, и на закваске 1940 года уверяют: вкусы отличаются. Но оба отличные. В последнем привлекает еще история продукта. Будем надеяться, что скоро йогурт «от 1940 года» смогут попробовать и гости Валаамской обители.